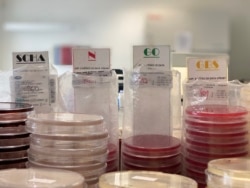
Пражская лаборатория, которая делает анализ на коронавирус

Эпидемия коронавируса и связанное с ней единовременное нахождение в реанимации большого количества людей, которым требуется искусственная вентиляция легких и аппараты ИВЛ, заставляет подумать о том, сколько мест в отделениях интенсивной терапии есть в охваченных пандемией странах. От их количества и доступности зависит спасение болеющих COVID-19. Но даже в исследованиях, которые проводились в последние годы, отмечалось: ясности в том, каким количеством мест в реанимациях располагают те или иные страны, нет.
Многие страны Европы включают в статистику не только койки непосредственно в реанимациях, но и места в отделениях острой неотложной помощи. Там могут быть дефибрилляторы и реанимационное оборудование, но оно не рассчитано на каждого пациента, а используется в зависимости от проблемы, с которой сталкиваются в том или ином случае врачи. В таких отделениях, как правило, не размещают реанимационных больных: они предназначены для проведения анализов, исследований и диагностики, для стабилизации состояния (например, после операции), и обычно в течение 48 часов пациентов отсюда переводят в обычную больничную палату или выписывают домой.
Именно такие койки включает в статистику, например, Чехия, которая по показателям количества мест интенсивной терапии может сравниться с Францией – 11,6 койки на 100 тысяч населения. Количественно речь идет о приблизительно 1227 местах, но в это число входят как койки непосредственно в реанимациях, так и койки в отделениях промежуточной медицинской помощи, где оснащенность необходимым оборудованием для спасения критических больных ниже.
Можно сравнить и такие страны, как Россия и Германия. Если взглянуть на общие цифры, то, по данным Организации экономического сотрудничества и развития (OECD), в обеих странах приблизительно одинаковое количество имеющихся в распоряжении врачей мест в больничных отделениях. Россия даже немного опережает Германию по этому показателю. При этом Германия в Европейском союзе занимает первое место по количеству мест в реанимационных отделениях – на 100 тысяч человек здесь приходится 29,2 койки (для сравнения в Италии – 12,5, в Испании – 9,7). Но сколько больных коронавирусом в обеих странах могут спасти врачи?
Точного ответа на этот вопрос нет, но можно воспользоваться цифрами имеющегося медицинского оборудования. Оснащенность аппаратами магнитно-резонансной томографии, согласно OECD, в России – 4,9 на миллион жителей, Германия по этому показателю на третьем месте в мире (34,7 на 1 миллион жителей), аппаратов компьютерной томографии в России – 14 на 1 миллион жителей против 35 в Германии. В реанимационных отделениях Германии – почти 24 тысячи мест. В России в марте этого года, по данным издания "Медвестник", которое в своей статье опирается на итоги недавно проведенной оценки российского Минздрава, развернуты 12 тысяч реанимационных коек – при том что население России больше, чем население Германии.
Вот еще один пример. В последние недели довольно распространенным является мнение о том, что высокий уровень смертности от коронавируса в Италии связан с тем, что почти четверть населения этой страны – люди пожилого возраста. Однако в 2018 году средний возраст немцев был 46 лет, а итальянцев – 46,3. При этом показатели смертности от коронавируса в Италии – 124,16 на миллион населения, а в Германии – 2,48. Наряду со значительной разницей в количестве мест в реанимациях еще одним объяснением может быть то, что в Германии эпидемия началась приблизительно на неделю позднее.
"У нас – недостаток мест в реанимациях", – рассказал изданию The Moscow Times пульмонолог Василий Штабницкий. – Считается, что 10 процентов всех доступных в больницах коек должны быть в реанимационных отделениях. Но в России этот показатель около 5 процентов. Это означает, что больницы не готовы к резкому скачку числа пациентов в критическом состоянии". Об этом было известно еще в ноябре 2018 года. Тогда заместитель руководителя Росздравнадзора Ирина Серегина говорила, что в 51 субъекте РФ было недостаточное количество коек для стационарного лечения больных ОРВИ и гриппом, а в 60 регионах для таких пациентов не хватало мест в реанимациях для лечения осложнений. Аппараты для обогащения кислородом крови (ЭКМО), которые применяются для лечения тяжелых пациентов с COVID-19, в 22 субъектах страны тогда вообще отсутствовали. Через год после этого заявления, в октябре минувшего года, эксперты отмечали, что в России – недостаток специалистов, способных применять этот метод лечения. ЭКМО спасает 50% жизней при легочной недостаточности.
Количество мест в больницах и реанимационных отделениях в Европе, по данным Всемирной организации здравоохранения, снижалось на протяжении последних десятилетий, несмотря на то что во многих исследованиях говорилось о необходимости их увеличения – из-за стареющего населения. В России с 1992 года число больничных коек снизилось на треть.
Недостаток мест в реанимациях пока больше всего ощутили Испания и Италия. В первой при общем объеме 5607 пациентов в критическом состоянии из-за COVID-19 (по состоянию на 31 марта. – Прим. РС) есть только 4479 реанимационных коек, во второй больных в критическом состоянии меньше (3981), чем количество мест в реанимациях (7750). Тем не менее, распространение вируса в разных регионах неодинаково, а задыхающимся больным требуется немедленное подключение к ИВЛ.
Аппарат искусственной вентиляции легких превратился в самое важное оборудование во время нынешней пандемии COVID-19. Во время недавней проверки российского Минздрава их насчитали 33 тысячи штук, при этом в некоторых регионах был недостаток еще в начале эпидемии. По данным издания "Проект", в Калужской области нехватка аппаратов ИВЛ составляет 86 процентов, в Тверской – 78 процентов, а в Воронежской, Костромской и Ростовской областях есть только половина необходимого количества. Лучше всего оснащены Алтай, Москва, Калмыкия и республика Коми.
В Италии, первой в Европе столкнувшейся с недостатком аппаратов ИВЛ, к их производству подключили армию, но даже благодаря этому в месяц удается произвести не более 500 штук.
Несмотря на очевидный недостаток мест в реанимациях и аппаратов для вентиляции легких и обогащения крови кислородом во многих странах Европы и мира, с коронавирусом можно бороться и другими способами. Пример тому – Южная Корея, которая располагает не таким уж высоким количеством коек в реанимациях, 10,6 – столько же, сколько в Италии. В этой стране снижения количества случаев заражения удалось достичь благодаря нескольким мерам. Практически с самого начала эпидемии проводилось повсеместное тестирование: анализы брали прямо на улице, в мобильных пунктах, появившихся в тех городах, где регистрировали больше всего случаев. Эпидемия коронавируса в Корее началась в феврале, но к 20 марта было сделано более 316 тысяч тестов.
Ношение медицинских масок в этой стране не было обязательным, но большинство людей использовали их добровольно в общественном транспорте, магазинах и в местах скопления людей. Правительство призывало жителей страны оставаться дома и участвовать в богослужениях онлайн. Врачи изолировали всех, контактировавших с больными, а их местонахождение во время карантина отслеживалось благодаря специальным онлайн-приложениям. Несмотря на то что эпидемия коронавируса в Южной Корее началась еще в феврале, благодаря этим мерам общее количество случаев заражения коронавирусом до сих пор не превышает 10 тысяч.
Южная Корея разработала эти превентивные меры для сдерживания распространения вируса давно. Впервые с подобной проблемой здесь столкнулись во время эпидемии подобного коронавирусу MERS. Местный предприниматель в 2015 году посетил три страны Ближнего Востока, а после возвращения ему долго не могли поставить диагноз и вынуждены были перевозить из одной больницы в другую, пока не выяснили наконец, чем он болен. За это время он один заразил 186 человек – персонал и посетителей больниц, других пациентов. 36 человек умерли, а в карантине тогда оказались 17 тысяч человек.